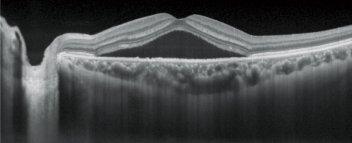

Nidek RS-3000 Advance 2
Features
- Providing a comprehensive solution for retina and glaucoma analysis
- Accurate image capture with a SLO-based eye tracer
- Selectable OCT sensitivity that allows acquisition of B-scan images through media opacities
- Tracing HD for accurate averaging of up to 120 image
- Glaucoma analysis with wide-area normative database 9 x 9 mm
- High resolution AngioScan OCT-Angiography image
SLO-based eye tracer
Real time compensation for eye movement with SLO-based eye tracer results in more accurate scans, ensuring higher image quality and maximum reproducibility

Retina analysis
 Retinal Mode
Retinal Mode
Choroidal Mode
Choroidal Mode
Selectable OCT sensitivity
Selection of the appropriate OCT sensitivity allows acquisition of B-scan images through media opacities.
 Ultra-fine
Ultra-fine
 Fine
Fine
 Regular
Regular
Tracing HD Plus
The tracing HD plus function traces involuntary eye movements to maintain the same scan location on the SLO image for accurate image capture. This function allows accurate averaging of up to 120 images.
Glaucoma analysis
 9x9 Normative Database (Macula)
9x9 Normative Database (Macula)
 6x6 Normative Database (Disc)
6x6 Normative Database (Disc)
Glaucoma progression

Long axial length normative database (optional software)
Details are available in the long axial length normative database page.
AngioScan (optional)
More information can be found here

Multimodal imaging
Various OCT modalities can be registered with microperimetry captured by NIDEK MP-3.
 OCT-Angiography Microperimetry
OCT-Angiography Microperimetry
 Normative DB + Microperimetry
Normative DB + Microperimetry
 Thickness Map + Microperimetry
Thickness Map + Microperimetry

Proud Distributors of








